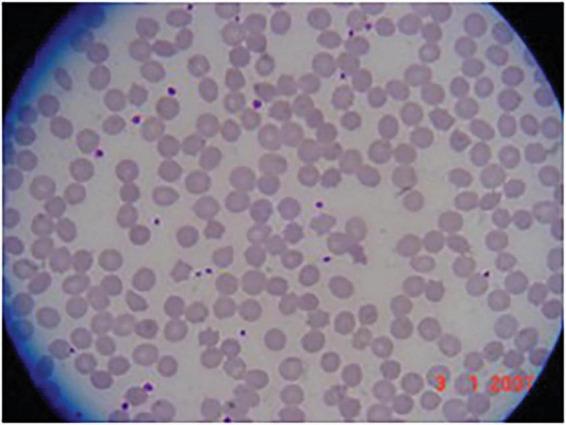
https://cdn.ncbi.nlm.nih.gov/pmc/blobs/f708/11417094/63fa4f51c508/fnins-18-1408105-g002.jpg

XK 病(麦克劳德综合征)的多种表现:一个包含新观察结果及对既往报道家系最新情况的病例系列
The protean presentations of XK disease (McLeod syndrome): a case series with new observations and updates on previously reported families.
作者信息
Walker Ruth H, Barreto Mariana, Bateman James R, Bustamante M Leonor, Chiu Graham, Feitell Scott, Frey Beat M, Guerra Patricio, Guerrero Sofia, Jung Hans H, Maldonado Fernando, Meyer Eduardo, Miranda Marcelo, McFarland Emelie, Oates Patricia, Ochoa Gorka, Olsson Karin, Paucar Martin, Proschle Jonatan Alvarez, Sammler Esther M, Troncoso Monica, Wu-Wallace Rachel, Young Leo, Vege Sunitha, Westhoff Connie M, Danek Adrian
机构信息
Department of Neurology, James J. Peters Veterans Affairs Medical Center, New York, NY, United States.
Department of Neurology, Mount Sinai School of Medicine, New York, NY, United States.
出版信息
Front Neurosci. 2024 Sep 9;18:1408105. doi: 10.3389/fnins.2024.1408105. eCollection 2024.
XK disease is a very rare, multi-system disease, which can present with a wide spectrum of symptoms. This disorder can also be identified pre-symptomatically with the incidental detection of serological abnormalities when typing erythrocytes in peripheral blood, or on other routine laboratory testing. Increasing awareness of this disorder and improved access to genetic testing are resulting in increasing identification of affected patients and families. Here we provide updates to some previously-reported families and patients and provide additional clinical details. We also report four new cases with a variety of presentations, one of whom had a novel mutation.
XK病是一种非常罕见的多系统疾病,可表现出广泛的症状。在外周血红细胞分型时,或在其他常规实验室检测中,通过偶然发现血清学异常也可在出现症状前识别这种疾病。对这种疾病的认识不断提高,以及基因检测的可及性改善,使得越来越多受影响的患者和家庭得以被识别。在此,我们提供一些之前报道过的家庭和患者的最新情况,并提供更多临床细节。我们还报告了4例具有不同表现的新病例,其中1例有新的突变。